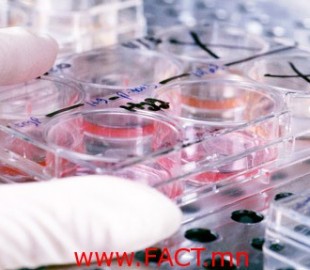
42361b_2103_x678

Category : Сайхан мэдээ (9)

2014 оны 1 сарын 06
Германы Хессе мужийн хамгийн том хот Франкфурт руу шууд нислэгтэй болно

2014 оны 1 сарын 06
Цалингийн нэмэгдлийг ирэх сард олгоно

2014 оны 1 сарын 04
Багш нарт мөнгөн урамшуулал олгох журам хэрэгжиж эхэллээ

2014 оны 1 сарын 04
Монгол улсын 2013 оны шилдэг 10 бүтээн байгуулалтыг нэрлэжээ

2014 оны 1 сарын 04
ЮНЕСКО-гийн дэлхийн түүх соёлын өвд бүртгэгдсэн Монгол улсын өвүүд

2013 оны 12 сарын 31
2014 он их зөнч Нострадамусын зөгнөлөөр
2013 оны 12 сарын 27
Хавдрыг эмчлэх шинэ төхөөрөмжтэй болжээ

2013 оны 12 сарын 26
Асрамжийн газрын хүүхдүүд шинэ жилээ тэмдэглэлээ

2013 оны 12 сарын 26
4 ихрийн ээж 4 сая төгрөгөө гардлаа
- «
- 1
- 2
- 3
- 4
- 5
- 6
- 7
- 8
- 9
- 10
- 11
- 12
- 13
- 14
- 15
- 16
- 17
- 18
- 19
- 20
- 21
- 22
- 23
- 24
- 25
- 26
- 27
- 28
- 29
- 30
- 31
- 32
- 33
- 34
- 35
- 36
- 37
- 38
- 39
- 40
- 41
- 42
- 43
- 44
- 45
- 46
- 47
- 48
- 49
- 50
- 51
- 52
- 53
- 54
- 55
- 56
- 57
- 58
- 59
- 60
- 61
- 62
- 63
- 64
- 65
- 66
- 67
- 68
- 69
- 70
- 71
- 72
- 73
- 74
- 75
- 76
- 77
- 78
- 79
- 80
- 81
- 82
- 83
- 84
- 85
- 86
- 87
- 88
- 89
- 90
- 91
- 92
- 93
- 94
- 95
- 96
- 97
- 98
- 99
- 100
- 101
- 102
- 103
- 104
- 105
- 106
- 107
- 108
- 109
- 110
- 111
- 112
- 113
- 114
- 115
- 116
- 117
- 118
- 119
- 120
- 121
- 122
- 123
- 124
- 125
- 126
- 127
- 128
- 129
- 130
- 131
- 132
- 133
- 134
- 135
- 136
- 137
- 138
- 139
- 140
- 141
- 142
- 143
- 144
- 145
- 146
- 147
- 148
- 149
- 150
- 151
- 152
- 153
- 154
- 155
- 156
- 157
- 158
- 159
- 160
- 161
- 162
- 163
- 164
- 165
- 166
- 167
- 168
- 169
- 170
- 171
- 172
- 173
- 174
- 175
- 176
- 177
- 178
- 179
- 180
- 181
- 182
- 183
- 184
- 185
- 186
- 187
- 188
- 189
- 190
- 191
- 192
- 193
- 194
- 195
- 196
- 197
- 198
- 199
- 200
- 201
- 202
- 203
- 204
- 205
- 206
- 207
- 208
- 209
- 210
- 211
- 212
- 213
- 214
- 215
- 216
- 217
- 218
- 219
- 220
- 221
- 222
- 223
- 224
- 225
- 226
- 227
- 228
- 229
- 230
- 231
- 232
- 233
- 234
- 235
- 236
- 237
- 238
- 239
- 240
- 241
- 242
- 243
- 244
- 245
- 246
- 247
- 248
- »
- МЭДЭЭЛЛИЙН САЙТУУД
- BOLOD.MN
- ZALUUCOM.MN
- FACT.MN
- TUR.MN
- TONSHUUL.MN
- CHUHAM.MN
- ENE.MN
- MISS.MN
- SCANDAL.MN
- DAYARMONGOL.MN
- GUREN.MN
- WEBS.MN
- DURSAMJ.MN
- ORD.MN
- TEEVERCHID.MN
- OTOCH.MN
- XAXA.MN
- WINDOW.MN
- NUTAG.MN
- KINGNEWS.MN
- ARDIINELCH.MN
- GUUR.MN
- VIPEXPO.MN
- SETGUUL.MN
- PAPARATSI.MN
- ZUV.MN
- ARSLAN.MN
- ECONEWS.MN
- AMJILT.COM
- JIRGEE.MN
- SHUURHAI.MN
- TSAG.MN
- TUMEN.MN
- UNEN.MN
- DEED.MN
- SURVALJ.MN
- ULSTURCH.MN
- CONTROL.MN
- UPDOWN.MN
- TOIM.MN
- GEREG.MN
- ONTSLOKH.MN
- INET.MN
- FOCUSMEDEE.MN
- VIPZUUCH.MN
- VIPZAR.MN
- ZARSONIN.MN
- VIPNEWS.MN
- SHOPSHOP.MN
- EHLEL.MN
- CAAKMEDEE.MN
- LIKEMEDEE.MN
- SHUURKHAIMEDEE.MN
- NEWSTODAY.MN
- UNDESNIIMEDEE.MN
- AMJILTNEWS.MN
- УЛААНБААТАР ХОТ, ДҮҮРГИЙН МЭДЭЭ МЭДЭЭЛЛИЙН САЙТУУД
- baganuur.nutag.mn
- bagakhangai.nutag.mn
- bayangol.nutag.mn
- bayanzurkh.nutag.mn
- nalaikh.nutag.mn
- skhd.nutag.mn
- sbd.nutag.mn
- khanuul.nutag.mn
- chingeltei.nutag.mn
- ОРОН НУТГИЙН САЙТУУД
- Arkhangai.mn
- Bayan-ulgii.nutag.mn
- Bayankhongor.nutag.mn
- Bulgan.nutag.mn
- Govialtai.mn
- Govisumber.nutag.mn
- Darkhannews.mn
- Dornogovi.mn
- Dundgovi.mn
- Choibalsan.mn
- Zavkhan.nutag.mn
- Uvurkhangai.nutag.mn
- Umnugovi.nutag.mn
- Sukhbaatar.nutag.mn
- Selenge.nutag.mn
- Tuv.nutag.mn
- Uvs.nutag.mn
- Khovd.nutag.mn
- Khuvsgul.nutag.mn
- Khentiid.mn
- Erdenetmedee.mn
- Erdenetkhot.mn




